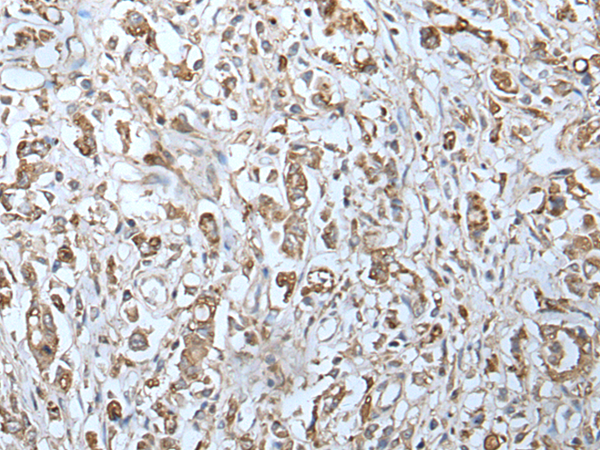

别名:9-27; CD225; IFI17; LEU13; DSPA2a应用:WB,IHC
反应种属:Human, Mouse
规格:50μl/100μl
| Description |
|---|
| Interferons (IFNs) are potential antitumor agents, as they exhibit antiproliferative and differentiating properties, in addition to functioning in the defense against microbial infections. IFN exposure induces the regulation of expression levels of cellular proteins that mediate the pleiotropic effects of interferons. These effects may be mediated by soluble factors or by cell-cell interactions involving specific membrane proteins. The IFITM family of proteins are transmembrane proteins so named because their expression is IFN-inducible. IFITM proteins have been found upregulated in human colorectal carcinomas. Both mouse IFITM1 (also known as CD225) and IFITM3 demonstrate expression on the cell surfaces of primordial germ cells in a developmentally-regulated manner. They presumably modulate cell adhesion and influence cell differentiation. IFITM1 activity is required for primordial germ cell transit, and IFITM1 acts as a repulsive molecule by repelling non-IFITM1-expressing primordial germ cells from the mesoderm into the endoderm. |
| Specification | |
|---|---|
| Aliases | 9-27; CD225; IFI17; LEU13; DSPA2a |
| Swissprot | P13164 |
| WB Predicted band size | 14 kDa |
| Host/Isotype | Rabbit IgG |
| Storage | Store at 4°C short term. Aliquot and store at -20°C long term. Avoid freeze/thaw cycles. |
| Species Reactivity | Human, Mouse |
| Immunogen | Synthetic peptide of human IFITM1 |
| Formulation | pH7.4 PBS, 0.05% NaN3, 40% Glycerol |
| Application | |
|---|---|
| WB | 1/200-1/1000 |
| IHC | 1/25-1/100 |
| ELISA | 1/5000-1/10000 |
![]() |
Gel: 12%SDS-PAGE, Lysate: 40 μg, Lane 1-2: K562 and HepG2 cell lysates, Primary antibody: P05881(IFITM1 Antibody) at dilution 1/200, Secondary antibody: Goat anti rabbit IgG at 1/8000 dilution, Exposure time: 30 seconds |
![]() |
The image is immunohistochemistry of paraffin-embedded Human thyroid cancer tissue using P05881(IFITM1 Antibody) at dilution 1/20. (Original magnification: ×200) |
![]() |
The image is immunohistochemistry of paraffin-embedded Human gastric cancer tissue using P05881(IFITM1 Antibody) at dilution 1/20. (Original magnification: ×200) |
本公司的所有产品仅用于科学研究或者工业应用等非医疗目的,不可用于人类或动物的临床诊断或治疗,非药用,非食用。
暂无评论
本公司的所有产品仅用于科学研究或者工业应用等非医疗目的,不可用于人类或动物的临床诊断或治疗,非药用,非食用。
中文

发表回复